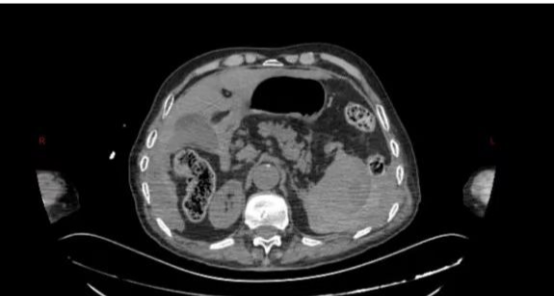

互联网新闻信息许可证服务编号:61120190002
陕西互联网违法和不良信息举报电话:029-63907152
2025-10-23 18:10:50 来源:阳光网-阳光报
阳光讯(记者 张伟)近日,宝鸡市人民医院肝胆胰脾外科为一位86岁迟发性脾破裂患者成功实施了腹腔镜下脾切除术。整个手术过程顺利,仅用时1个多小时,使用了五个1-2厘米的小切口,便成功完成了手术。术后患者恢复良好,已康复出院。

这是一位男性患者,来院就诊时家属代诉,老人4天前不慎摔倒,自觉无碍便未及时就医,3小时前突发左上腹剧痛并伴恶心呕吐,便紧急前往宝鸡市人民医院急诊科就诊。
急诊行CT检查提示:脾脏密度不均匀升高,考虑脾破裂。在就诊过程中,患者逐渐出现了心率增快、血压降低,行腹腔穿刺抽出不凝血,结合患者既往病情及辅助检查,考虑脾破裂的可能性极高。
患者病情危重,医院立即启动绿色通道,急诊科、肝胆胰脾外科、麻醉手术科等科室共同协作,将病人由急诊抢救室直接转运至手术室实施急诊手术治疗。
术前,肝胆胰脾外科主任金上博提出:患者高龄,使用传统开腹行脾切除术,手术切口往往需要20-30厘米甚至更长,对患者创伤极大。即便患者能够成功手术,也极易因为术后各种并发症导致患者病情恶化,甚至危及患者生命。
经过科内团队讨论后最终决定采用腹腔镜微创技术为患者实施脾切除术。该技术相比传统开腹手术来讲,对患者创伤更小,仅使用数个小切口即可完成手术,术后患者各类并发症相较于传统开腹手术的发生概率更低,但微创手术对术者的技术水平有着更加严格的要求。
术中,探查可见患者脾脏包膜下巨大血肿并包裹脾脏,包膜表面可见裂口,并伴有活动性出血,考虑迟发性脾破裂。由于患者年龄较大,必须尽量将手术时间缩短,否则随着手术时间的延长,患者术中术后出现麻醉风险及各类并发症的可能将大大增加。然而,脾脏周围密布着脾动脉、胃短动脉等各式各样的血管,如同布满了引线的火药库,想要快速、精准分离脾脏周围组织与血管更是难上加难,即使1毫米的偏差都有可能引发难以控制的大出血。

患者在术前已经出现了休克征象,如果术中再次出现出血等情况,极有可能造成难以挽回的结果。科主任金上博与副主任张晓宾通力合作,凭借高超的手术技术及丰富的手术经验,不到1小时即完成了脾脏切除,整个手术过程仅用时1个多小时。术中患者生命体征稳定,病人平稳完成手术。术后,患者被送往重症医学科监护治疗,当晚即脱机拔管,第二天早晨便由重症医学科转回普通病房,并很快康复出院。
病例专家说
分析该患者的成功救治过程,宝鸡市人民医院肝胆胰脾外科主任金上博特别提醒,以下几点需要了解和掌握:
一、迟发性脾破裂:高龄患者跌倒外伤后的隐匿危机。脾破裂可分为即时性与迟发性脾破裂两类,后者约占外伤性脾破裂的10%-20%,多发于外伤后48小时至7天。本例患者因受伤后自感无特殊不适,未就医详细检查,导致脾脏包膜下血肿持续扩大最终破裂。高龄患者因血管脆性增加、凝血功能减退,更易发生迟发性破裂。典型表现为左上腹持续性疼痛(可向左肩放射)、恶心呕吐及进行性面色苍白,严重者迅速进展至失血性休克,甚至危及患者生命,导致患者死亡。
二、腹腔镜微创技术:高龄手术的突破性选择。相较于传统开腹手术,腹腔镜技术呈现更多显著优势:1.精准干预:团队运用腔镜影像导航系统,不仅能够高清放大视野,精准操作,也能够探查腹腔其他脏器及器官,减少隐匿性损伤的可能;2.微创获益:数个1-2厘米的小切口可显著降低术后疼痛评分与切口感染率,并大大降低术后各类并发症如肠梗阻、肠粘连、切口疝等的发生概率;3.时效控制:精湛手术技艺将手术时长控制在1个多小时,能够有效规避高龄患者长时间麻醉带来的各类麻醉风险。
三、多学科通力合作:构筑围术期安全防线。针对患者的突发病情,医院急诊科、肝胆胰脾外科、手术室、重症医学科、呼吸内科、心血管内科等科室通力合作,能够共同为患者术中及术后病情管理及治疗保驾护航,守护患者生命安康。